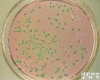
氯化镁孔雀绿<em>肉汤</em>（MM，RV <em>Medium</em>）

TB - Powder Medium (Terrific Broth) (肉汤/TB肉汤)
- 品牌:AppliChem
- 型号:A0974_1000-1L
- 产地:德国
- 供应商:厦门慧嘉生物科技有限公司
- 供应商报价:询价
- 标签:TB - Powder Medium (Terrific Broth) (极品肉汤/TB肉汤)、TB - Powder Medium (Terrific Broth) (极品肉汤/TB肉汤)价格、TB - Powder Medium (Terrific Broth) (极品肉汤/TB肉汤)厂家、详见说明、、厦门慧嘉生物科技有限公司